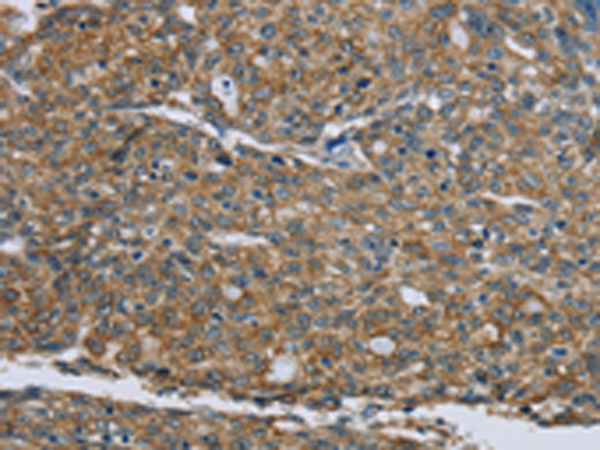
KRT5

提醒成功

搜索
产品中心
Product Center条件筛选
全部清除
-
Category

-
Host

-
Antibody Type

-
Application

-
Conjugation

-
Research Field

-
Modified

-
Targets

-
Antibody Pair

-
Host/Isotype

-
Species Reactivity

-
加入对比加入购物车
-
加入对比加入购物车
-
加入对比加入购物车
-
加入对比加入购物车
-
加入对比加入购物车
-
加入对比加入购物车
-
 货号:P00170
货号:P00170KRT81
应用:WB,IHC 别名:HB1; Hb-1; KRTHB1; MLN137; ghHkb1; hHAKB2-1 反应种属:Human, Mouse目录价 ¥1980
加入对比加入购物车 -
加入对比加入购物车
-
加入对比加入购物车
-
加入对比加入购物车
-
加入对比加入购物车
-
加入对比加入购物车














 微信/QQ登录
微信/QQ登录


 首页
首页